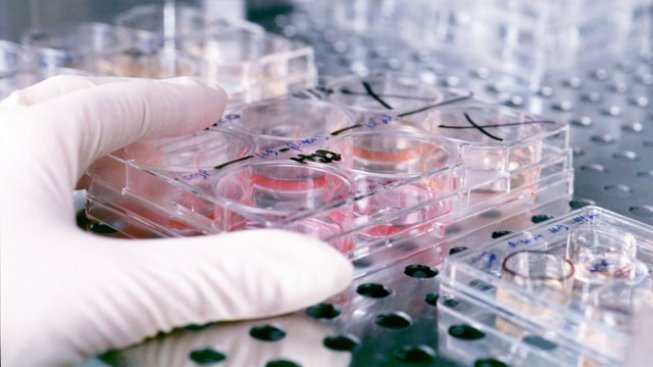
Becas de movilidad José Castillejo para jóvenes doctores

La Obra Social la Caixa convoca cinco becas para realizar un Doctorado Internacional en cualquiera de los ocho centros de investigación españoles, acreditados con el distintivo de excelencia Severo Ochoa. Una oportunidad única en la vida con la que podrás cursar tus estudios en un centro de referencia y rodeado de grandes profesionales. Sin duda, el impulso definitivo que tu carrera profesional necesita.
¿Quieres saber más detalles de este programa de becas Internacionales La Caixa-Severo Ochoa? En ese caso toma nota de cómo puedes participar.